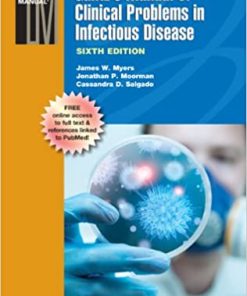
Gantzs Manual of Clinical Problems in Infectious Disease 6th Ed

Shop
Showing 11161–11169 of 26071 results
-

GAME OF SCONES
د.إ63.00 Add to cart Quick View Compare -

Game Theory in Biology Concepts and Frontiers
د.إ705.00 Add to cart Quick View Compare -

Gamebird Medicine and Management
د.إ632.00 Add to cart Quick View Compare -

Gamma Knife Neurosurgery
Call for Price Price Ask Via WhatsApp Quick View Compare -

Gamma Knife Neurosurgery in the Management of Intracranial Disorders
Call for Price Price Ask Via WhatsApp Quick View Compare -

Gamma Knife Neurosurgery in the Management of Intracranial Disorders II
Call for Price Price Ask Via WhatsApp Quick View Compare -
Sale!
Gantzs Manual of Clinical Problems in Infectious Disease 6th Ed
Original price was: د.إ471.00.د.إ250.00Current price is: د.إ250.00. Add to cart Quick View Compare -

Gap Junction Protocols
د.إ646.00 Add to cart Quick View Compare


